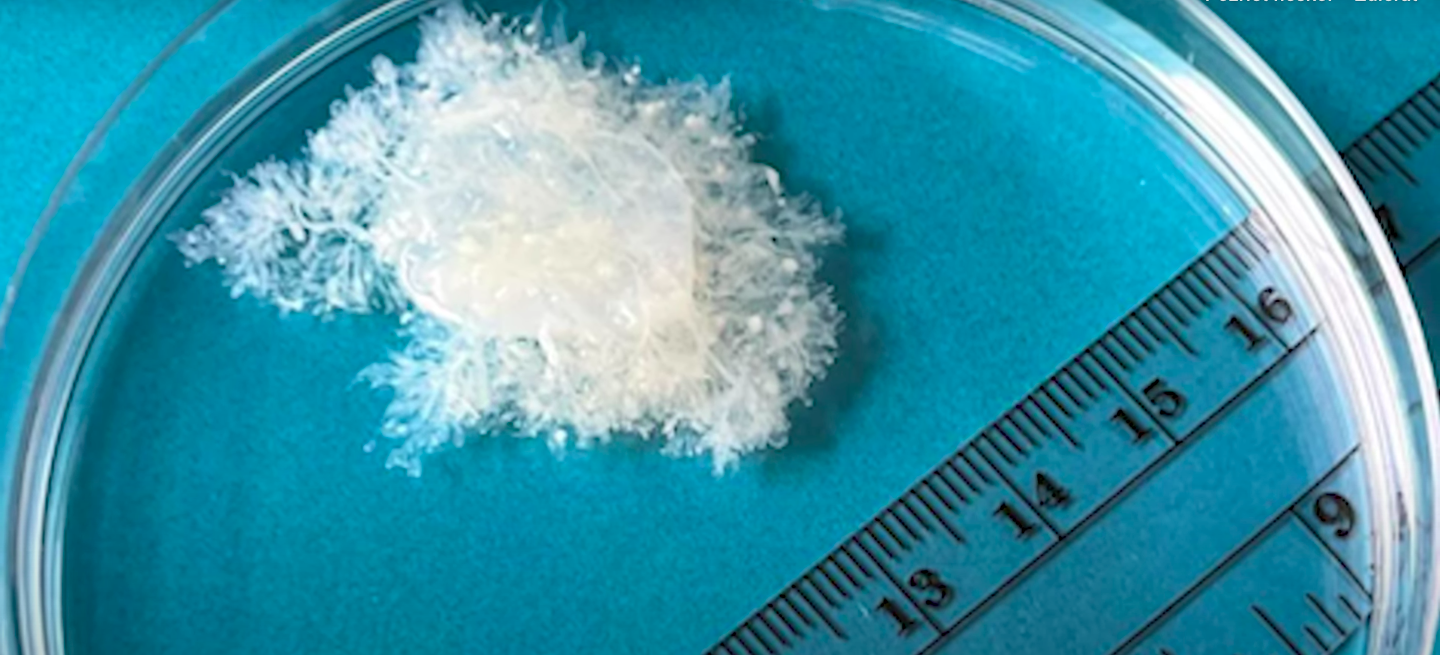
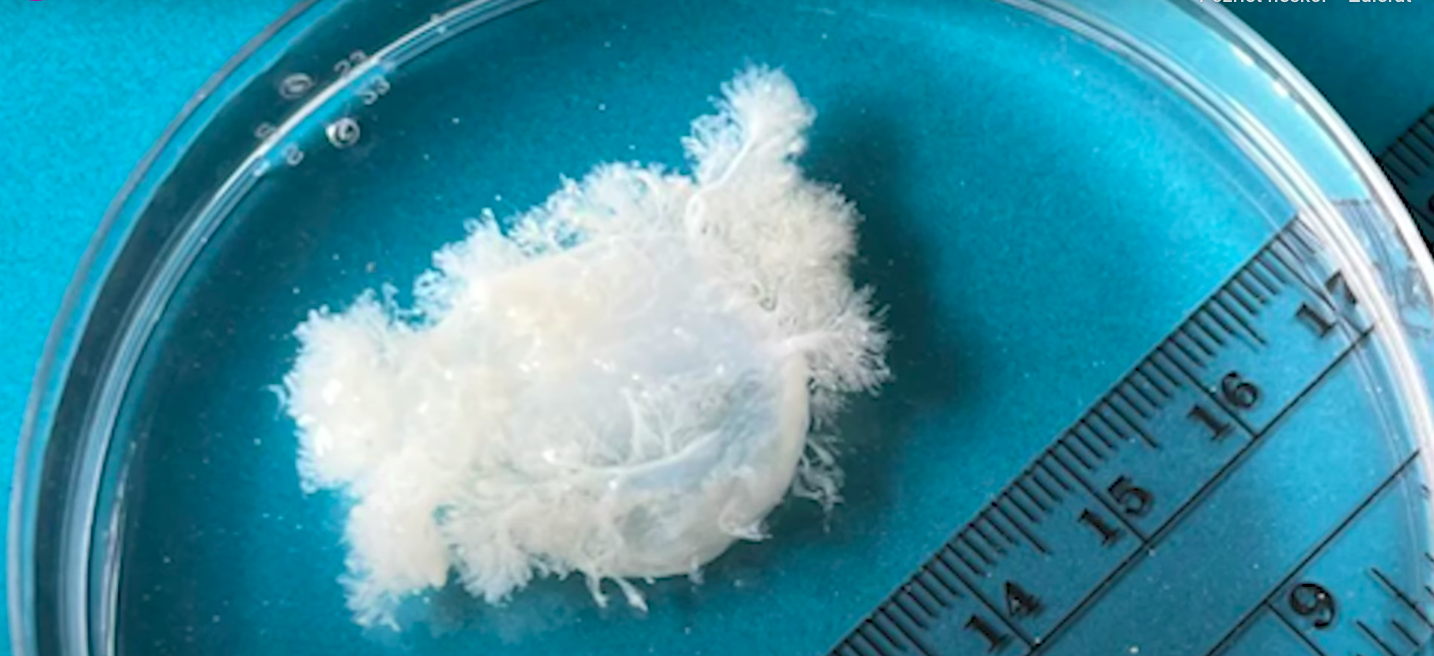
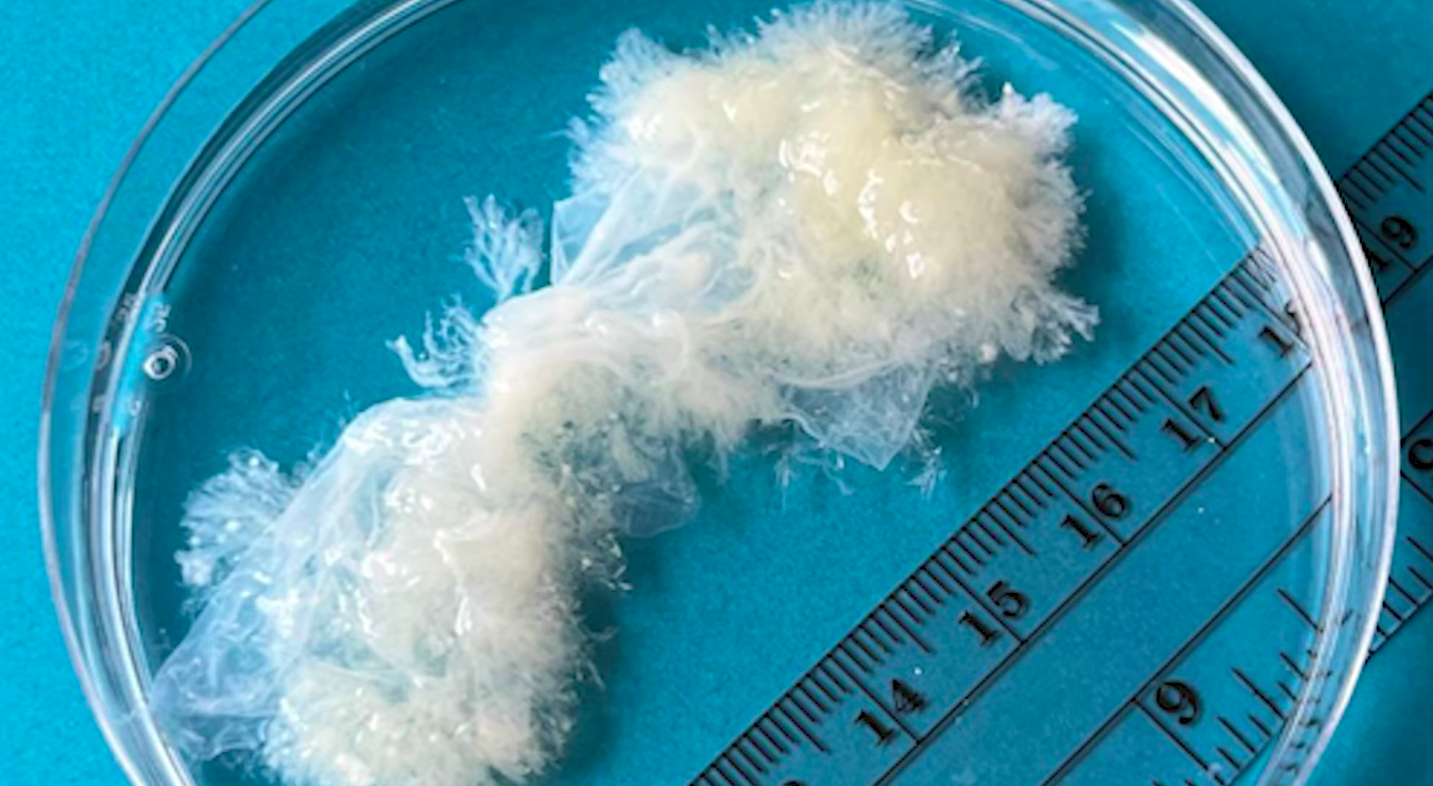
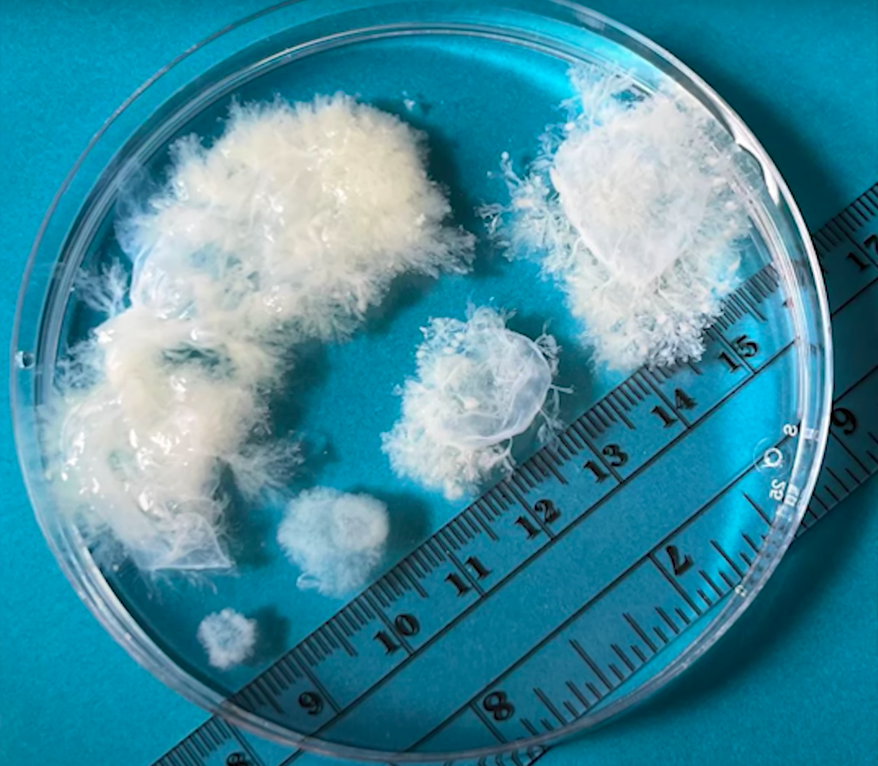

Potratené tkanivo nie je žiadne dieťa. Vedci rozmetali najväčšiu lož pro-life hnutí
- Tkanivo sa až do deviateho týždňa tehotenstva nepodobá na embryo
- Niektoré pacientky chcú po extrakcii tkanivo vidieť
Potraty sa momentálne zakazujú vo viacerých štátoch, výnimkou nie je ani 14 krajín USA. Často sa tak deje najmä preto, že interrupcia sa už v mnohých štátoch nepovažuje za zdravotnú procedúru, ale za otázku morálky.
V amerických krajinách sú potraty zakázané až od 15. týždňa tehotenstva, avšak vo viacerých štátoch sú zakázané už od úplného počiatočného štádia otehotnenia, uviedol portál The Guardian.
Klinickí lekári a aktivisti zo siete MYA Network už počas pandémie odborne študovali a skúmali, ako v skutočnosti vyzerá tkanivo v prvých deviatich týždňoch tehotenstva.
Doktor Joan Fleischman, ktorý patrí pod sieť MYA Network, používa na odstránenie tkanív z maternice jemné zariadenie, ktoré tkanivo odstráni, ale zároveň nepoškodí.
Tkanivo nevyzerá ako embryo
Takto vyzerá rané tehotenské tkanivo, konkrétne tkanivo z 5. týždňa tehotenstva. Tkanivo nie je väčšie ako 5 milimetrov, čo značí, že do tohto týždňa sa tkanivo zväčšuje každý týždeň len o jeden milimeter.

Ako uviedol The Guardian, niektorí pacienti chcú po extrakcii vidieť toto tkanivo. „Sú ohromení tým, ako to v skutočnosti vyzerá. Vtedy som si uvedomil, do akej miery prenikli do sveta obrázky na internete, ktoré ukazujú tkanivo ako ľudského tvora. Ľudia takmer neveria, že to v skutočnosti vyzerá takto,“ povedal doktor Fleischman.
Virálnymi sa stali obrázky na TikToku, mnohí muži aj ženy boli v šoku, keď uvideli niečo úplne iné, než čo im roky servírujú pro-life hnutia.
V šiestom týždni tehotenstva je tkanivo o niečo väčšie.

Počas šiesteho týždňa lekári hovoria, že počujú „tlkot srdca“, avšak v skutočnosti je to len elektrická aktivita buniek predtým, ako sa z nich skutočne srdce vytvorí.
Siedmy týždeň tehotenstva.
Tkanivo v siedmom týždni tehotenstva stále nemá žiadne viditeľné znaky embrya. Vak nemá ešte ani pol centimetra, pričom pacientky sa v tejto fáze boja prísť na potrat, pretože sa obávajú toho, čo videli na obrázkoch na internete, „Očakávajú, že uvidia malý plod s rukami, vyvinuté, miniatúrne dieťa,“ povedal Fleischman.
Povedal, že dokonca aj študenti medicíny a lekári nevedia, ako v skutočnosti „plod“ v ranom štádiu vyzerá. „Takto všadeprítomná je táto dezinformácia,“ dodal.
V ôsmom týždni tehotenstva sa ešte stále netreba rozhodovať medzi „vhodným či nevhodným časom“ na potrat.
Samozrejme, netreba vylučovať, že ide o veľmi emočne náročnú udalosť. Avšak lekári chcú, aby ľudia vedeli, čo sa vlastne na začiatku samotného tehotenstva odstraňuje.
„Potrat je lekárska starostlivosť. Rozhodnutie ísť na potrat je zložité, ale tieto informácie zobrazujúce tkanivo počas prvých 10. týždňov doslova chýbajú v našom bežnom chápaní toho, čo sa deje, a ľudia si zaslúžia presné informácie,“ hovorí Fleischman.
Deviaty týždeň tehotenstva.
Toto je gestačný vak deväťtýždňového tehotenstva. Práve ukázanie tohto tkaniva môže byť pre pacientky úľavou. „Ľudia často s nikým nehovoria o potrate. Robia veľmi tiché, súkromné rozhodnutie, pretože sa boja vidieť reakcie ostatných ľudí,“ tvrdí Fleischman.
Vyššie je niekoľko gestačných vakov na jednej Petriho miske, ktoré poukazujú na rast tkaniva od piateho po deviaty týždeň tehotenstva. Vak narastie každý deň o 1 milimeter.
Tehotenstvo počas prvých deviatich týždňov nemá „v sebe“ žiadne viditeľné embryo. Približne 85 % potratov v USA sa uskutoční pred 9. týždňom tehotenstva. Cieľom MYA Network je čeliť dezinformáciám, ktoré poukazujú na to, že pri skorom potrate spleť tkanív nevyzerá ako embryo.
Čítaj viac z kategórie: Zaujímavosti
Zdroje: The Guardian, MYA Network, YouTube/The Issue of Tissue